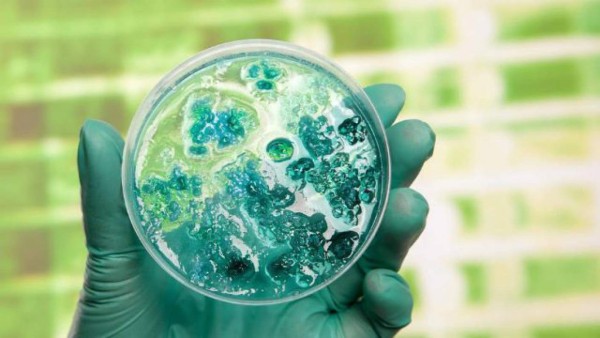
Las catástrofes del futuro en la tierra y Eric Cantona también se suma a las predicciones

Las catástrofes del futuro en la tierra y Eric Cantona también se suma a las predicciones
En plena gala previo al sorteo de la fase de grupos de la Champions 2019-20, el francés Eric Cantona sorprendió a todos al hablar del futuro de la humanidad, cree que habrá catástrofes por culpa de la ciencia, guerras y crímenes.
2019-08-31
-
 1 / 19En plena gala previo al sorteo de la fase de grupos de la Champions 2019-20, el francés Eric Cantona sorprendió a todos al hablar del futuro de la humanidad, cree que habrá catástrofes por culpa de la ciencia, guerras y crímenes.
1 / 19En plena gala previo al sorteo de la fase de grupos de la Champions 2019-20, el francés Eric Cantona sorprendió a todos al hablar del futuro de la humanidad, cree que habrá catástrofes por culpa de la ciencia, guerras y crímenes. -
 2 / 19El ex futbolista francés silenció totalmente el Forum Grimaldi de Mónaco el pasado jueves cuando recibió un reconocimiento de la UEFA por toda su trayectoria en el fútbol, tuvo un corto discurso, pero que fue suficiente para dejar a todos con la boca abierta.
2 / 19El ex futbolista francés silenció totalmente el Forum Grimaldi de Mónaco el pasado jueves cuando recibió un reconocimiento de la UEFA por toda su trayectoria en el fútbol, tuvo un corto discurso, pero que fue suficiente para dejar a todos con la boca abierta. -
 3 / 19'Nosotros somos para los Dioses lo mismo que las moscas para los niños: nos matan por deporte', inició diciendo en su discurso, esta frase filosófica pertenece al personaje Gloucester de 'El Rey Lear', una obra de principio del 1600 que redactó William Shakespeare.
3 / 19'Nosotros somos para los Dioses lo mismo que las moscas para los niños: nos matan por deporte', inició diciendo en su discurso, esta frase filosófica pertenece al personaje Gloucester de 'El Rey Lear', una obra de principio del 1600 que redactó William Shakespeare. -
 4 / 19'Pronto, la ciencia no solo será capaz de frenar el envejecimiento de las células, sino que también las reparará y así seremos eternos. Solo los accidentes, los crímenes, las guerras nos matarán, pero desafortunadamente los crímenes y las guerras se multiplicarán', predijo en lo que muchos han llamado un discurso apocalíptico.
4 / 19'Pronto, la ciencia no solo será capaz de frenar el envejecimiento de las células, sino que también las reparará y así seremos eternos. Solo los accidentes, los crímenes, las guerras nos matarán, pero desafortunadamente los crímenes y las guerras se multiplicarán', predijo en lo que muchos han llamado un discurso apocalíptico.
-
 5 / 19'Amo el fútbol. Gracias', cerró el breve comentario y despertó unos aplausos en el auditorio aunque los presentes no abandonaron los rostros de desconcierto.
5 / 19'Amo el fútbol. Gracias', cerró el breve comentario y despertó unos aplausos en el auditorio aunque los presentes no abandonaron los rostros de desconcierto.
-
 6 / 19Sin embargo esta predicción con respecto al futuro, se suma a muchas predicciones que distintas personalidades han realizado con respecto al futuro, muchos de ellos consideran que a mitad del presente siglo comenzarán a desatarse grandes catástrofes.
6 / 19Sin embargo esta predicción con respecto al futuro, se suma a muchas predicciones que distintas personalidades han realizado con respecto al futuro, muchos de ellos consideran que a mitad del presente siglo comenzarán a desatarse grandes catástrofes. -
 7 / 19En 1950, en las zonas urbanas vivían poco menos de 750 millones de personas. Hoy en día, esa cifra se ha disparado a más de 4.000 millones, lo cual representa más de la mitad de la población de todo el mundo, y la tendencia va a continuar, pronostica el artículo, agregando que 'para mediados de siglo, alrededor de 6.300 millones de personas vivirán en las ciudades', cita un artículo del medio ruso RT.
7 / 19En 1950, en las zonas urbanas vivían poco menos de 750 millones de personas. Hoy en día, esa cifra se ha disparado a más de 4.000 millones, lo cual representa más de la mitad de la población de todo el mundo, y la tendencia va a continuar, pronostica el artículo, agregando que 'para mediados de siglo, alrededor de 6.300 millones de personas vivirán en las ciudades', cita un artículo del medio ruso RT. -
 8 / 19¿Qué significa esto? Que habrá graves problema en pocos años, para 2050 el aire podría llegar a ser 'espeso por la contaminación', lo cual provocaría el aumento de las enfermedades respiratorias.
8 / 19¿Qué significa esto? Que habrá graves problema en pocos años, para 2050 el aire podría llegar a ser 'espeso por la contaminación', lo cual provocaría el aumento de las enfermedades respiratorias.
-
 9 / 19Según un reciente informe de la Organización para la Cooperación y el Desarrollo Económico (OCDE), el número de muertes causadas por la contaminación del aire se elevará para 2050, matando a más de seis millones de personas cada año.
9 / 19Según un reciente informe de la Organización para la Cooperación y el Desarrollo Económico (OCDE), el número de muertes causadas por la contaminación del aire se elevará para 2050, matando a más de seis millones de personas cada año.
-
 10 / 19Escasez de agua: En la actualidad 1.100 millones de personas carecen de acceso al agua, y 2.500 millones de personas (36% de la población mundial) viven en regiones que experimentan 'estrés hídrico'.
10 / 19Escasez de agua: En la actualidad 1.100 millones de personas carecen de acceso al agua, y 2.500 millones de personas (36% de la población mundial) viven en regiones que experimentan 'estrés hídrico'.
-
 11 / 19Es posible que para mediados de siglo, más de la mitad de la población mundial no tenga acceso adecuado al agua. Cerca de 2.000 millones de personas, sobre todo en los países de Oriente Medio y el norte de África, vivirán en zonas con escasez absoluta de agua, según el Instituto Internacional de Gestión del Agua.
11 / 19Es posible que para mediados de siglo, más de la mitad de la población mundial no tenga acceso adecuado al agua. Cerca de 2.000 millones de personas, sobre todo en los países de Oriente Medio y el norte de África, vivirán en zonas con escasez absoluta de agua, según el Instituto Internacional de Gestión del Agua.
-
 12 / 19Pescados que comemos pueden extinguirse: Hoy en día el 87% de los bancos de peces del mundo están clasificados como 'sobreexplotados' o 'completamente explotados'. Si la humanidad sigue pescando al ritmo actual, todas las poblaciones de peces podrían extinguirse para el año 2050, según un informe de 2010 de la ONU.
12 / 19Pescados que comemos pueden extinguirse: Hoy en día el 87% de los bancos de peces del mundo están clasificados como 'sobreexplotados' o 'completamente explotados'. Si la humanidad sigue pescando al ritmo actual, todas las poblaciones de peces podrían extinguirse para el año 2050, según un informe de 2010 de la ONU.
-
 13 / 19Hambruna: Cada década, el calentamiento global disminuirá la cantidad de comida que somos capaces de producir en un 2%, lo cual significa que en los próximos 10 años, vamos a perder 4,4 millones de toneladas de alimentos.
13 / 19Hambruna: Cada década, el calentamiento global disminuirá la cantidad de comida que somos capaces de producir en un 2%, lo cual significa que en los próximos 10 años, vamos a perder 4,4 millones de toneladas de alimentos.
-
 14 / 19Selvas tropicales: Cada año, perdemos gran parte de la selva tropical, el lugar de donde obtenemos muchos de los medicamentos que salvan vidas. La mayor parte de la deforestación es causada por la tala y la agricultura.
14 / 19Selvas tropicales: Cada año, perdemos gran parte de la selva tropical, el lugar de donde obtenemos muchos de los medicamentos que salvan vidas. La mayor parte de la deforestación es causada por la tala y la agricultura. -
15 / 19Las súperbacterias matarán a 10 millones de personas: Actualmente, las infecciones que ya no responden a los medicamentos que una vez utilizamos están matando a 700.000 personas al año. Para 2050, ese número podría alcanzar los 10 millones de muertescada año, advierte la publicación, explicando que el problema de las bacterias resistentes a los antibióticos se ha visto agravado por un acceso demasiado 'liberal' a estos medicamentos.
15 / 19Las súperbacterias matarán a 10 millones de personas: Actualmente, las infecciones que ya no responden a los medicamentos que una vez utilizamos están matando a 700.000 personas al año. Para 2050, ese número podría alcanzar los 10 millones de muertescada año, advierte la publicación, explicando que el problema de las bacterias resistentes a los antibióticos se ha visto agravado por un acceso demasiado 'liberal' a estos medicamentos.
-
 16 / 19Demencia se triplicará: A medida que aumente la longevidad, tendremos que enfrentarnos cada vez más a las llamadas enfermedades de la vejez, siendo particularmente preocupantes las que aún no sabemos diagnosticar o tratar, como la demencia. Para 2050, el número de personas afectadas por demencia se triplique, pasando de 36 millones de personas a la alarmante cifra de 115 millones, según un reciente informe de la Organización Mundial de la Salud.
16 / 19Demencia se triplicará: A medida que aumente la longevidad, tendremos que enfrentarnos cada vez más a las llamadas enfermedades de la vejez, siendo particularmente preocupantes las que aún no sabemos diagnosticar o tratar, como la demencia. Para 2050, el número de personas afectadas por demencia se triplique, pasando de 36 millones de personas a la alarmante cifra de 115 millones, según un reciente informe de la Organización Mundial de la Salud.
-
 17 / 19Huracanes más fuertes: 'Mientras que nuestros abuelos habrían vivido una tormenta de la escala de Sandy, nuestros nietos podrán ver al menos 20 durante su vida', asevera el artículo de 'Business Insider'. El cambio climático, además de elevar el nivel del mar y causar el aumento de las temperaturas, también hará que las tormentas sean más intensas.
17 / 19Huracanes más fuertes: 'Mientras que nuestros abuelos habrían vivido una tormenta de la escala de Sandy, nuestros nietos podrán ver al menos 20 durante su vida', asevera el artículo de 'Business Insider'. El cambio climático, además de elevar el nivel del mar y causar el aumento de las temperaturas, también hará que las tormentas sean más intensas. -
 18 / 19Ciudades inundadas: El ascenso del nivel del mar causará inundaciones en las principales ciudades de todo el mundo. El crecimiento del nivel del agua se hará sentir de forma aguda en EE.UU., donde en 2050 la mayoría de las ciudades a lo largo de la costa noreste podrían ver más de 30 días de inundaciones cada año.
18 / 19Ciudades inundadas: El ascenso del nivel del mar causará inundaciones en las principales ciudades de todo el mundo. El crecimiento del nivel del agua se hará sentir de forma aguda en EE.UU., donde en 2050 la mayoría de las ciudades a lo largo de la costa noreste podrían ver más de 30 días de inundaciones cada año. -
 19 / 19Petróleo más caro: Con el aumento de la población mundial, crecerá la cantidad de casas y autos, lo cual provocará a su vez una mayor demanda de recursos energéticos. De acuerdo con un informe del HSBC, citado por 'Business Insider', si el consumo de energía global continúa al ritmo actual, en 2050 veremos un aumento del 110% en la demanda de petróleo, así como la duplicación de la demanda total de energía.
19 / 19Petróleo más caro: Con el aumento de la población mundial, crecerá la cantidad de casas y autos, lo cual provocará a su vez una mayor demanda de recursos energéticos. De acuerdo con un informe del HSBC, citado por 'Business Insider', si el consumo de energía global continúa al ritmo actual, en 2050 veremos un aumento del 110% en la demanda de petróleo, así como la duplicación de la demanda total de energía.







